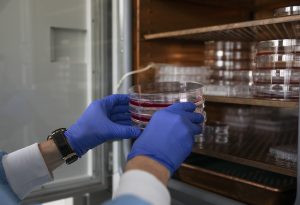

Plataformas de apoyo
Investigación
Desde el Área de Producción del Conocimiento e Innovación del IACS, 3 plataformas de temática estratégica agrupan y relacionan los servicios científico-técnicos con la actividad de investigación en las líneas prioritarias
Plataformas de apoyo
Plataforma de Medicina Personalizada de Precisión
Dentro de las acciones iniciadas para el desarrollo de la estrategia española de Medicina Personalizada, son prioritarios los tres nuevos programas de Medicina Predictiva, Ciencia de Datos y Medicina Genómica.
Esta plataforma agrupa el conocimiento clínico y científico a través del aprovechamiento de todos los datos que provienen del sistema sanitario, de los resultados de la investigación y de los servicios científico-técnicos de Genómica, Proteómica, Biobanco del Sistema de Salud de Aragón, Anatomía Patológica, Biocomputación y el Laboratorio Satélite de Apoyo al Diagnóstico y Refuerzo al Diagnóstico (LASARD)
Servicios Científico-Técnicos de la plataforma:
- Anatomía Patológica
- Biocomputación
- Proteómica
- Secuenciación y
Genómica Funcional
Otros servicios de apoyo de la plataforma:
- Biobanco
- LaSARD
Plataforma de terapias avanzadas
En el Plan Estratégico de Medicina Precisión del SNS, el Plan de abordaje de las Terapias Avanzadas en el Sistema Nacional de Salud (SNS) define los medicamentos de terapia avanzada como medicamentos de uso humano basados en genes (terapia génica), células (terapia celular somática) y tejidos (ingeniería tisular) haciendo especial énfasis en medicamentos de terapia celular somática (medicamentos CAR y otros).
La idea de la plataforma es agrupar el conocimiento clínico y científico para la investigación, desarrollo y producción de este tipo de terapias uniendo de forma sinérgica los servicios científico técnicos de Modificaciones Genéticas y Cultivos Celulares, Separación Celular y Citometría, Microscopía e Imagen, y el nuevo laboratorio transversal de desarrollo y producción de terapias avanzadas que se pretende crear en un futuro cercano aprovechando las convocatorias específicas para la financiación en este ámbito.
Servicios Científico-Técnicos de la plataforma:
- Modificaciones Genéticas y Cultivos Celulares
- Microscopía e Imagen
- Separación Celular y
Citometría
Plataforma de Biomodelos
En esta plataforma, estrechamente relacionada con la estrategia que ha comenzado a desplegarse por la Plataforma Nacional de Biobancos y Biomodelos del ISCIII de la que formamos parte, la idea es agrupar el conocimiento clínico, científico y técnico de los grupos de investigación y de los Servicios Científico-Técnicos de Imagen Médica y Fenotipado, Cirugía Experimental y Animalario para el desarrollo de modelos (actuales y nuevos) y técnicas con alto valor añadido y estándares de calidad y ética, que apoyen la base de las plataformas anteriores en cuanto a investigación y desarrollo.
Servicios Científico-Técnicos de la plataforma:
- Animalario
- Cirugía experimental
- Imagen Médica
y Fenotipado
Los servicios científico técnicos de nuestras plataformas
Los Servicios Científico Técnicos (SCT) son instalaciones destinadas a dar soporte a investigadores, equipos, grupos de investigación, instituciones y empresas con el fin de potenciar la investigación en el área biomédica. Integran infraestructuras y grandes equipamientos dedicados a la realización de técnicas especializadas
Otros servicios de apoyo
Noticias de los SCT
Más de 40 especialistas se formarán en las instalaciones de Cirugía Experimental en el marco del Congreso de la Sociedad Española de Cirugía Plástica, Reparadora y Estética
Los talleres precongresuales de la 58ª edición de este congreso se desarrollarán en el CIBA, elegido por la organización por la sobresaliente dotación en infraestructura con la que cuenta, destacando el moderno bloque quirúrgico y la adecuada ubicación en el territorio nacional
Cuarenta especialistas se formarán en cirugía de mano y microcirugía en el CIBA
Las instalaciones de Cirugía Experimental, que comparten el IACS y la Universidad de Zaragoza en el CIBA, acogerán las prácticas del curso Micro y Mano «Pedro Marquina», que celebra este año su XXXIX edición, del 10 al 13 de marzo
El IACS participa un año más en las actividades del Día de la Mujer y la Niña en la Ciencia
Científicas del IACS se desplazarán a distintos centros educativos para participar en las actividades de conmemoración del 11F
Desde el IACS se lleva también a cabo una campaña en la web divulga.iacs.es, con el objetivo de visibilizar la labor de las mujeres científicas del Instituto, y despertar vocaciones entre las más pequeñas